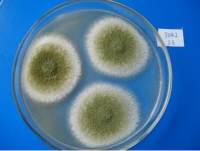
P1kc 噬菌体，P1kc phage

万千商家帮你免费找货
0 人在求购买到急需产品
- 详细信息
- 技术资料
- 库存:
60
- 英文名:
详见说明书
- 保质期:
详见说明书
- 供应商:
上海谷研
- 保存条件:
详见说明书
- 规格:
250g
产品名称:1/2MS培养基(不含琼脂和蔗糖)
规格:250g
用途:用于植物组织培养(不含琼脂和蔗糖)
详情介绍
名称:1/2MS培养基(不含琼脂和蔗糖)
规格:250g
用途:用于植物组织培养(不含琼脂和蔗糖)
培养基形态 :
1 、 干粉培养基为粉末剂型
2 、干粉培养基的色泽
3 、干粉培养基的气味
培养基特点:
1 、 非使用过程的终端产品
2 、使用方便
3 、质量稳定
4 、标准统一
5 、 国际化、标准化
公司供应的所有产品仅用于科研实验。
合成培养基:
1 合成培养基是由已知化学成分的营养物质组成的。
2 由于微生物对营养要求的不同,它可能完全由无机盐或无机盐加有机化合物组成。
3 这种合成培养基的配方成分都是已知的,所以只要配制过程的操作严格要求,各批培养基的质量可做到稳定一致。如:无机盐、淀粉和生长因子所组成的基础培养基中,加入 谷氨酸和胱氨酸,即使接种极少量的细菌也能生长。
主要成分:
1 .1/2MS培养基(不含琼脂和蔗糖)一般基础培养基的配方中仅含肉浸液、 蛋白胨、氯化钠和琼脂等基本营养物质。
2 .但在细菌诊断工作中,常需利用选择性培养基和鉴别培养基,此类培养基配中除了基本营养成分外,还需加入抑菌剂、指示剂、凝固剂、血液、糖等生化试剂,使病原菌容易生长,并呈现它们的特点,同时抑制杂菌生长,以利于细菌的分离与鉴别。

操作步骤:
(一)准确称量试剂:根据不同的菌类和用途,选择适宜的培养基,培养基所需试剂必须纯净。
(二)校正pH值:将称量好的培养基各种成分放入容器内,标记划线,加热溶解,补充水分,测定酸碱度,常用pH6.8~8.0的精密试纸或酸度计测定。用1N NaOH和1N HCl调节pH值到适宜范围内。
(三)过滤:将玻璃漏斗置铁架上,再用纱布夹棉花或用滤纸放在漏斗中,将上述培养基倒入其中过滤至透明。
(四)分装:将过滤后的培养基分装于中试管或三角瓶内(试管内每支装5mL;三角瓶中装100~150ml),塞好棉塞用牛皮纸包扎好,准备灭菌。
(五)灭菌:培养基的灭菌,常用高压蒸汽灭菌法。一般微生物的营养细胞在水中煮沸后即被杀死,但细菌的芽胞有较强的抗热性,须经高压蒸汽灭菌才能达到彻底灭菌的目的。根据蒸汽温度随压力升高而上升的原理,即压力越大,蒸汽温度就越高。因此,在同一温度条件下,采用高压蒸汽灭菌比干热灭菌法效果要好。而且在湿热情况下,菌体吸收水分后,其蛋白质易于凝固变性,因为蒸汽的穿透力强,杀菌效果好。
培养基的分类:
(1)合成培养基。合成培养基的各种成分完全是已知的各种化学物质。这种培养基的化学成分清楚,组成成分精确,重复性强,但价格较贵,而且微生物在这类培养基中生长较慢。如高氏一号合成培养基、察氏(Czapek)培养基等。
(2)天然培养基。由天然物质制成,如蒸熟的马铃薯和普通牛肉汤,前者用于培养霉菌,后者用于培养细菌。这类培养基的化学成分很不恒定,也难以确定,但配制方便,营养丰富,所以常被采用。
(3)半合成培养基。在天然有机物的基础上适当加入已知成分的无机盐类,或在合成培养基的基础上添加某些天然成分,如培养霉菌用的马铃薯葡萄糖琼脂培养基。这类培养基能更有效地满足微生物对营养物质的需要。
多药耐药相关蛋白8抗体英文全称Cluster of differentiation 8英文简称CD8检测范围6372nmol/L-120U/mL
糖蛋白GNTVA抗体英文全称DYRK1A英文简称DYRK1A检测范围6373nmol/L-120u/L
IGFBP2结合蛋白/迁移和侵润抑制蛋白抗体英文全称Enzyme of Bacillus英文简称FOB检测范围6374nmol/L-120U/L
MSH同源蛋白1样蛋白抗体英文全称Total amino acid英文简称T-AA检测范围6375nmol/L-400μg/mL
膜相关环指蛋白6抗体英文全称Sodium Coupled Neutral Amino Acid Transporter 1英文简称SNAT1检测范围6376nmol/L-10ng/ml
单氨氧化酶A抗体英文全称Sodium Coupled Neutral Amino Acid Transporter 2英文简称SNAT2检测范围6377nmol/L-10ng/ml
同源盒蛋白Meis1抗体英文全称Sodium Coupled Neutral Amino Acid Transporter 3英文简称SNAT3检测范围6378nmol/L-16ng/ml
丝裂原活化蛋白激酶组织蛋白1抗体英文全称Sodium Coupled Neutral Amino Acid Transporter 4英文简称SNAT4检测范围6379nmol/L-4000pg/ml
盐丙卡因标准品 规格:200mg 英文名称:Prilocaine Hydrochloride
头孢地尼相关物质A标准品 规格:10mg 英文名称:
外消旋依法韦仑标准品 规格:20mg 英文名称:
左氧氟沙星杂质C标准品 规格:25mg 英文名称:
D-基半乳糖盐盐标准品 规格:300mg 英文名称:Galactosamine Hydrochloride
多非利特相关物质A标准品 规格:20mg 英文名称:Dofetilide Related Compound A
去酰毛花苷丙标准品 规格:100mg 英文名称:Deslanoside
缬更昔韦盐盐标准品 规格:500mg 英文名称:Valganciclovir Hydrochloride
标准品 规格:200mg 英文名称:Metolazone
奥氮平杂质C标准品 规格:5mg 英文名称:
1/2MS培养基(不含琼脂和蔗糖)托吡酯产品CAS:
规格含量:20mg/支
莪术二酮对照品
结构式:莪术二酮对照品
分子式: C15H24O2
分子量: 236.35
用途:莪术二酮对照品(Curdione)供中国药典 2010 年版一部莪术油、保妇康栓等项下鉴别或含量测定用,含量以 99.8%计。
包装及装量: 棕色安瓿瓶,约 20mg/支
类别:中检所
保存条件:冷藏保存
规格:250g
用途:用于植物组织培养(不含琼脂和蔗糖)
详情介绍
名称:1/2MS培养基(不含琼脂和蔗糖)
规格:250g
用途:用于植物组织培养(不含琼脂和蔗糖)
培养基形态 :
1 、 干粉培养基为粉末剂型
2 、干粉培养基的色泽
3 、干粉培养基的气味
培养基特点:
1 、 非使用过程的终端产品
2 、使用方便
3 、质量稳定
4 、标准统一
5 、 国际化、标准化
公司供应的所有产品仅用于科研实验。
合成培养基:
1 合成培养基是由已知化学成分的营养物质组成的。
2 由于微生物对营养要求的不同,它可能完全由无机盐或无机盐加有机化合物组成。
3 这种合成培养基的配方成分都是已知的,所以只要配制过程的操作严格要求,各批培养基的质量可做到稳定一致。如:无机盐、淀粉和生长因子所组成的基础培养基中,加入 谷氨酸和胱氨酸,即使接种极少量的细菌也能生长。
主要成分:
1 .1/2MS培养基(不含琼脂和蔗糖)一般基础培养基的配方中仅含肉浸液、 蛋白胨、氯化钠和琼脂等基本营养物质。
2 .但在细菌诊断工作中,常需利用选择性培养基和鉴别培养基,此类培养基配中除了基本营养成分外,还需加入抑菌剂、指示剂、凝固剂、血液、糖等生化试剂,使病原菌容易生长,并呈现它们的特点,同时抑制杂菌生长,以利于细菌的分离与鉴别。

操作步骤:
(一)准确称量试剂:根据不同的菌类和用途,选择适宜的培养基,培养基所需试剂必须纯净。
(二)校正pH值:将称量好的培养基各种成分放入容器内,标记划线,加热溶解,补充水分,测定酸碱度,常用pH6.8~8.0的精密试纸或酸度计测定。用1N NaOH和1N HCl调节pH值到适宜范围内。
(三)过滤:将玻璃漏斗置铁架上,再用纱布夹棉花或用滤纸放在漏斗中,将上述培养基倒入其中过滤至透明。
(四)分装:将过滤后的培养基分装于中试管或三角瓶内(试管内每支装5mL;三角瓶中装100~150ml),塞好棉塞用牛皮纸包扎好,准备灭菌。
(五)灭菌:培养基的灭菌,常用高压蒸汽灭菌法。一般微生物的营养细胞在水中煮沸后即被杀死,但细菌的芽胞有较强的抗热性,须经高压蒸汽灭菌才能达到彻底灭菌的目的。根据蒸汽温度随压力升高而上升的原理,即压力越大,蒸汽温度就越高。因此,在同一温度条件下,采用高压蒸汽灭菌比干热灭菌法效果要好。而且在湿热情况下,菌体吸收水分后,其蛋白质易于凝固变性,因为蒸汽的穿透力强,杀菌效果好。
培养基的分类:
(1)合成培养基。合成培养基的各种成分完全是已知的各种化学物质。这种培养基的化学成分清楚,组成成分精确,重复性强,但价格较贵,而且微生物在这类培养基中生长较慢。如高氏一号合成培养基、察氏(Czapek)培养基等。
(2)天然培养基。由天然物质制成,如蒸熟的马铃薯和普通牛肉汤,前者用于培养霉菌,后者用于培养细菌。这类培养基的化学成分很不恒定,也难以确定,但配制方便,营养丰富,所以常被采用。
(3)半合成培养基。在天然有机物的基础上适当加入已知成分的无机盐类,或在合成培养基的基础上添加某些天然成分,如培养霉菌用的马铃薯葡萄糖琼脂培养基。这类培养基能更有效地满足微生物对营养物质的需要。
多药耐药相关蛋白8抗体英文全称Cluster of differentiation 8英文简称CD8检测范围6372nmol/L-120U/mL
糖蛋白GNTVA抗体英文全称DYRK1A英文简称DYRK1A检测范围6373nmol/L-120u/L
IGFBP2结合蛋白/迁移和侵润抑制蛋白抗体英文全称Enzyme of Bacillus英文简称FOB检测范围6374nmol/L-120U/L
MSH同源蛋白1样蛋白抗体英文全称Total amino acid英文简称T-AA检测范围6375nmol/L-400μg/mL
膜相关环指蛋白6抗体英文全称Sodium Coupled Neutral Amino Acid Transporter 1英文简称SNAT1检测范围6376nmol/L-10ng/ml
单氨氧化酶A抗体英文全称Sodium Coupled Neutral Amino Acid Transporter 2英文简称SNAT2检测范围6377nmol/L-10ng/ml
同源盒蛋白Meis1抗体英文全称Sodium Coupled Neutral Amino Acid Transporter 3英文简称SNAT3检测范围6378nmol/L-16ng/ml
丝裂原活化蛋白激酶组织蛋白1抗体英文全称Sodium Coupled Neutral Amino Acid Transporter 4英文简称SNAT4检测范围6379nmol/L-4000pg/ml
盐丙卡因标准品 规格:200mg 英文名称:Prilocaine Hydrochloride
头孢地尼相关物质A标准品 规格:10mg 英文名称:
外消旋依法韦仑标准品 规格:20mg 英文名称:
左氧氟沙星杂质C标准品 规格:25mg 英文名称:
D-基半乳糖盐盐标准品 规格:300mg 英文名称:Galactosamine Hydrochloride
多非利特相关物质A标准品 规格:20mg 英文名称:Dofetilide Related Compound A
去酰毛花苷丙标准品 规格:100mg 英文名称:Deslanoside
缬更昔韦盐盐标准品 规格:500mg 英文名称:Valganciclovir Hydrochloride
标准品 规格:200mg 英文名称:Metolazone
奥氮平杂质C标准品 规格:5mg 英文名称:
1/2MS培养基(不含琼脂和蔗糖)托吡酯产品CAS:
规格含量:20mg/支
莪术二酮对照品
结构式:莪术二酮对照品
分子式: C15H24O2
分子量: 236.35
用途:莪术二酮对照品(Curdione)供中国药典 2010 年版一部莪术油、保妇康栓等项下鉴别或含量测定用,含量以 99.8%计。
包装及装量: 棕色安瓿瓶,约 20mg/支
类别:中检所
保存条件:冷藏保存
风险提示:丁香通仅作为第三方平台,为商家信息发布提供平台空间。用户咨询产品时请注意保护个人信息及财产安全,合理判断,谨慎选购商品,商家和用户对交易行为负责。对于医疗器械类产品,请先查证核实企业经营资质和医疗器械产品注册证情况。
 技术资料
技术资料暂无技术资料 索取技术资料
1/2MS培养基(不含琼脂和蔗糖)
询价